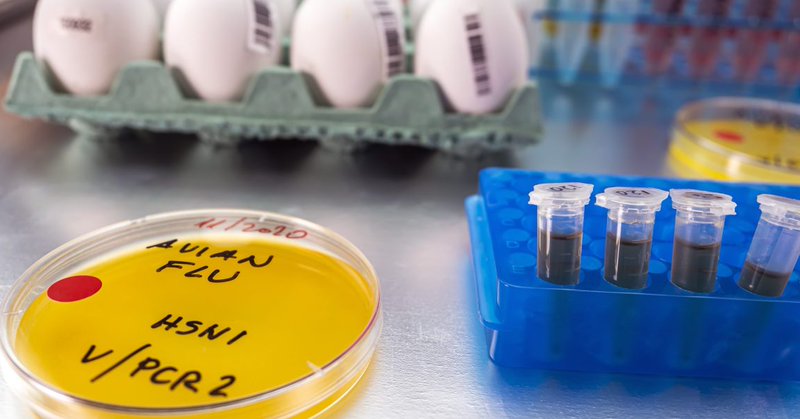
Tweet card summary image

Debby van Riel
@DebbyvanRiel
Followers
1K
Following
3K
Media
54
Statuses
787
Associate Professor @ Viroscience -Erasmus MC - The Netherlands #Influenza #Enterovirus #SARS-CoV-2 #Systemic #Pathogenesis #CNSdisease #Pathology #WomeninSTEM
Joined December 2013
International Women’s Day 2022! I have the honor to work with these amazing scientists! They are creative, curious, enthusiastic, funny, ambitious and above all a TEAM! Thanks @LisaBauerVirus @LonnekevNes @bmlaksono @Syriam0803 &Feline Benavides. # IWD @MarionKoopmans
4
4
47
#ESWI2025 🚀Extra call for abstracts in Molecular Virology – now open! 🚨 Deadline is 31 July 2025 at 23:59 CET 📢 Don’t miss your chance to contribute — submit now! ➡️ https://t.co/ElmSMMiKD3
0
5
5
Early career scientists in the field of respiratory virus infections: Check out these awards 👇🏼 Submit your application and join us at the ESWI conference in October in Valencia. Feel free to share 😀
🌟 #ESWI 🏆 are open for #EarlyCareerScientists! 🌟 ✨ Young Scientist Vaccine Innovation Award 📅 Deadline: 28 February 2025 ℹ️ Eligibility https://t.co/inpAKurRhs 📽️ Hear from @GuthmillerJenna our inspiring 2023 winner. Will you be next? Showcase your innovation!
1
9
12
BirdFlu will be the next pandemic unless health officials take 6 critical steps, experts say https://t.co/HVV7nqn2JX
@USDA @CDCgov @CDCDirector @RobertKennedyJr @SenSanders @zalaly @EricTopol @mvankerkhove @angie_rasmussen @RickABright @vivek_murthy @VirusesImmunity
fortune.com
The time for urgency, the experts say, is now.
7
17
69
The SARS-CoV-2 spike protein was recently found to localize in an unusual place outside the brain. This localization pattern might explain the neuroinflammatory symptoms experienced during: - SARS-CoV-2 infection - Long COVID..🧵
20
328
927
gratulations team @DebbyvanRiel @miranda_graaf and others for this great collaborative grant!! Viruses like it sweet. https://t.co/ISvwX2aZqZ. .
nwo.nl
21 research consortia have the chance to reach a breakthrough thanks to funding from the Open Competition Domain Science - XL. From fundamental research on the effects of certain materials on the...
1
3
11
Looking forward to identify functional glycan receptor for influenza viruses, enteroviruses and noroviruses in respiratory, gastrointestinal and CNS tissues. Together with @LisaBauerVirus @miranda_graaf @bart_haagmans @RobertPdeVries1 @TheBoonsGroup and Karli Reiding.
I'm super excited that our consortium has been funded by the NWO! Can't wait to get started! @DebbyvanRiel @miranda_graaf @bart_haagmans @LisaBauerVirus @TheBoonsGroup @UU_Glycoscience @UUUIPS #glycotime
https://t.co/JRjZ3pHzx2
1
3
19
Check out our new preprint where we investigated the attachment and replication of a clade 2.3.4.4b HPAIV H5N1 isolate (Caspian Gull origin) in human respiratory tissues. https://t.co/dZscztGW8W
biorxiv.org
Background Highly pathogenic avian influenza (HPAI) H5 viruses of the A/Goose/Guangdong/1/1996 (GsGd) lineage pose significant global risks to wildlife, domestic animals, and humans. Recent cross-s...
1
2
11
13/ Special thanks to @LisaBauerVirus and @LonnekevNes , as they worked extremely hard on this project. Also thanks to all the co-authors ❤️ This might be my last post on X, but you can follow me on Bleusky @thijskuiken @MarionKoopmans @kakape
1
1
5
12/ This study shows that studying the attachment pattern (virushistochemistry) and replication kinetics in respiratory cultures are relatively easy methods to include in the phenotypic characterization of newly emerging influenza viruses, or variants thereof.
1
1
5
11/ It is important to monitor the circulation HPAI H5N1 viruses! Besides genomic surveillance, phenotypic characterization is essential as we cannot yet completely predict a phenotype based on genotype.
2
1
3
11/ We are not suggesting that clade 2.3.4.4b virus is (more) transmissible among humans. This is dependent on multiple factors of which we only studied attachment, replication and polymerase activity.
1
2
4
10/ More efficient attachment to and replication in respiratory epithelial cells of clade 2.3.4.4b virus might make it easier for the virus to cross the species barrier to humans. This would fit with the recent human cases detected.
1
1
4
9/ What does this means? Here some of our thoughts. Clade 2.3.4.4b H5 viruses have expanded the glycan receptors to which they can attach, compared to the representative H5N1-2005 virus. Which glycans, and where they are expressed in the human resp tract is unknown.
1
1
3
8/ Finally clade 2.3.4.4b H5N1 virus infection triggered in a type-I and -III IFN response. Of the measured pro-inflammatory cytokines only IP-10 could be detected, and f.e. not IL-6 and TNF, which was detected in the H3N2 virus infected cultures.
1
1
4
7/ The polymerase activity of 2.3.4.4b H5N1 virus was not higher than that of H5N1-2005 virus. The more efficient replication of 2.3.4.4b H5N1 virus in human epithelial cells was thus not associated with an increased polymerase activity.
1
1
3
6/ Infection was predominantly seen in ciliated epithelial cells. Abundant infection of clade 2.3.4.4b H5N1 virus in tr/br cultures resulted in loss of cilia, however, tight junctions stayed intact (based on ZO-1 expression). ZO-1 expression decreased in H3N2 infected cultures.
1
1
5
5/ Without attachment no infection, but attachment alone is not sufficient. In vitro, 2.3.4.4b H5N1 virus replicated to higher titers in nasal and trachea/bronchial epithelial cells than H5N1-2005. In the tracheal/bronchial epithelial cells even to similar titers as a H3N2 virus.
1
1
5
4/ In the lower respiratory tract clade 2.3.3.4b H5 virus attached more abundantly to the ciliated epithelial cells in the trachea, bronchus and bronchioles than 2.3.2.1 H5 virus, but not as abundant as a seasonal H3N2 virus.
1
1
4
3/First we showed that clade 2.3.4.4b H5 virus attached more abundantly to both the human upper and lower respiratory tract than a well-studied clade 2.3.2.1 H5 virus from 2005. However, attachment was not as abundant as an human H3N2 virus in the nasal turbinates.
1
2
4